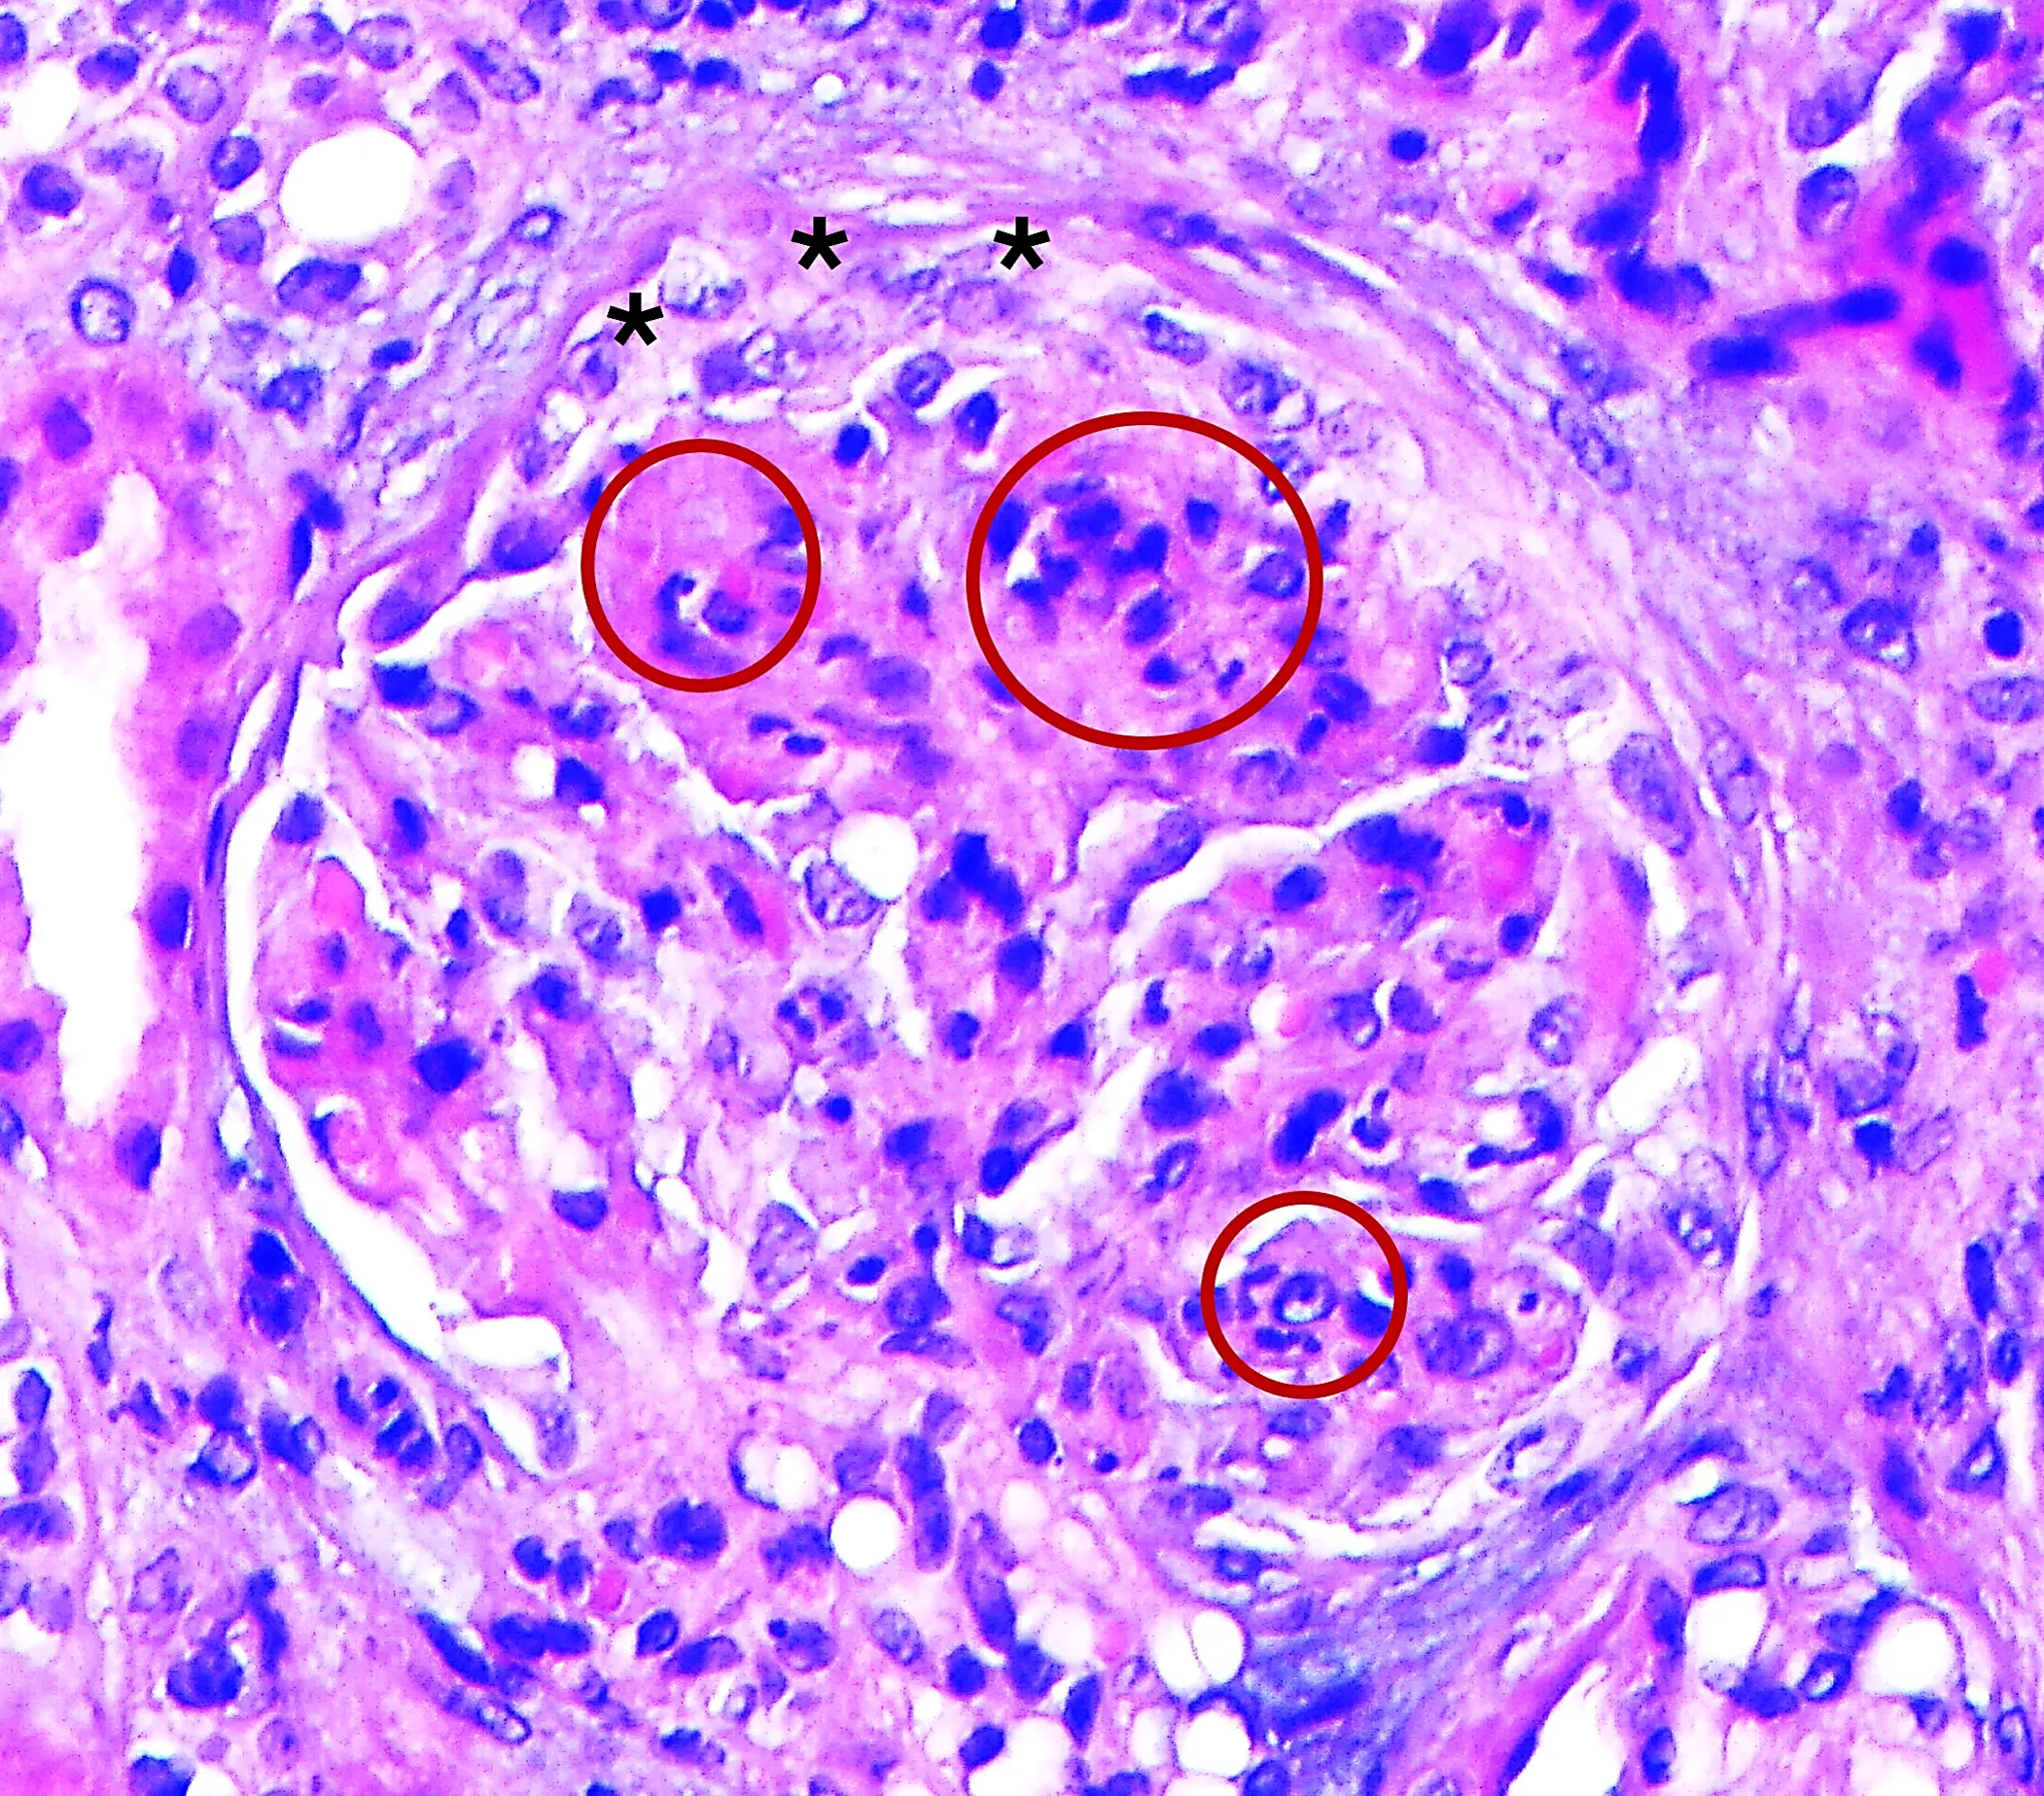
H&E con proliferación extracapilar fibrocelular en Glomerulopatía C3

ABRIL 22, 2026
Dr. Francisco Javier Díaz / Dr. Manuel Praga
Descripción de la patología
Enfermedad ultrarrara, causada por hiperactividad de la vía alterna (VA) del complemento que origina un depósito de C3 y otros productos de degradación del complemento en los capilares glomerulares1,2. La desregulación de la VA es causada por mutaciones en genes que codifican proteínas y/o reguladores de la VA (C3, factores H, I, B) en aproximadamente un 25 % de casos o por autoanticuerpos (Ac) contra reguladores de la VA (Ac anti-factor H, Ac estabilizadores de las convertasas C3 o C5). El Ac más frecuentemente detectado (40-80 % dependiendo del subtipo de GC3) es el factor nefrítico C3 (C3Nef), que estabiliza la convertasa C3 induciendo una hiperactividad constante de la VA1,2. En algunos casos no se encuentran anomalías genéticas ni Ac que expliquen la enfermedad. En pacientes adultos (>40-50 años) y ancianos la causa principal son gammapatías monoclonales (GM) que inducen una desregulación similar de la VA2. El diagnóstico se basa en la presencia de intensos depósitos de C3 en la inmunofluorescencia directa (IFD), exclusivos o predominantes3 (Imgs. 1-3).
|
Img. 1. IFD para C3c que muestra positividad granular intensa (3+) y difusa para C3 mesangial y en asas capilares. 40x. |
Img. 2. IFD para IgG negativa (0), con ausencia de tinción. 40x. |
Img. 3. IFD para IgG positiva granular débil (trazas, 1+) mesangial ( blanca) y focalmente en asas capilares ( ). 40x. |
La glomerulonefritis membranoproliferativa (GNMP) es el patrón histológico más frecuente (Imgs. 4 y 5), pero pueden observarse otros (mesangioproliferativo, extracapilar, glomeruloesclerosis segmentaria y focal o proliferativo endocapilar) (Img. 6). Se han establecido índices pronósticos basados en las características histológicas para valorar la actividad y la cronicidad de la enfermedad (C3 glomerulopathy histopathology index)4. Existen dos subtipos de GC3, según los hallazgos de la microscopía electrónica (ME)1,2:
- Enfermedad por depósitos densos (EDD): depósitos amorfos difusos y marcadamente electrodensos dentro de la membrana basal glomerular (Img. 7).
- Glomerulonefritis C3 (GNC3): depósitos subendoteliales, mesangiales y ocasionalmente subepiteliales (Img. 8).
|
Img. 4. H&E. Glomérulo con hipercelularidad endocapilar (O rojo) y proliferación mesangial (* rojo). Se aprecia engrosamiento de las asas capilares (→ rojo). 40x. |
Img. 5. Tinción de plata metenamina. Patrón de GNMP con presencia de desdoblamiento de la membrana basal glomerular ( → dobles contornos). 40x. |
Img. 6. H&E. Glomérulo con proliferación mesangial y endocapilar (O rojo). También se aprecia proliferación extracapilar fibrocelular (* rojo). 40x. |
|
Img. 7. MET con enfermedad por depósitos densos. Presencia de depósitos marcadamente electrodensos mesangiales (*blanco) y subendoteliales y en el espesor de la lámina densa (→ rojo). También se observa imagen de doble contorno (→ negro). 12000x. |
Img. 8. MET. Glomerulonefritis C3 con patrón ultraestructural de GNMP tipo I. Se observan depósitos subendoteliales (* amarillo) con imágenes de dobles contornos( → rojo). 16000x. |
Presentaciones más frecuentes
Se diagnostica sobre todo en niños y adolescentes. Las presentaciones clínicas son muy variables, predominando la proteinuria no nefrótica con microhematuria y función renal conservada, y el síndrome nefrótico completo. La hipocomplementemia C3 persistente se observa en el 50-65 % de los casos y tiene un enorme valor diagnóstico1,2.
Presentaciones más infrecuentes: formas rápidamente progresivas (asociadas a proliferación extracapilar) y nefritis agudas postinfecciosas (hipertensión, hematuria, hipocomplementemia C3 manifiesta)1. Muy raramente, la presentación es similar a la de un síndrome hemolítico-urémico (deterioro agudo de función renal con anemia hemolítica y microangiopatía trombótica [MAT]), observándose en la biopsia renal lesiones de MAT además de la inmunofluorescencia de C35. En pacientes con un diagnóstico inicial de GNMP por inmunocomplejos (GNMP-IC) (depósito de inmunoglobulinas [Ig] y C3 en la IFD) primaria o idiopática (no asociada con ninguna causa demostrable), se ha descrito la transformación en una GNC3 en una segunda biopsia. Aunque no demostrado, se considera que son casos de GNC3 con depósitos transitorios de Ig en el seno de procesos infecciosos intercurrentes6. Como manifestaciones extrarrenales pueden encontrarse drusas retinianas y lipodistrofia parcial adquirida7,8.
Puntos clave para el diagnóstico diferencial
Clínicos
- Anomalías renales con hipocomplementemia C3 persistente: en ausencia de lupus, elevada sospecha de GC3.
- La hipocomplementemia C3 es frecuente, pero no constante, por lo que su ausencia no debe descartar la enfermedad.
- En aquellos pacientes diagnosticados de glomerulonefritis aguda postinfecciosa (con o sin biopsia renal) en quienes persista la hematuria o la proteinuria más allá de 3-4 meses de evolución y no se observe una normalización en los niveles séricos de C3, se debe sospechar de una GC39.
- En pacientes adultos y ancianos (>40-50 años) con diagnóstico de GC3 confirmado por biopsia es obligatorio descartar la existencia de GM.
Histológicos
- El diagnóstico definitivo está basado en la biopsia renal.
- El patrón histológico de GNMP es el más frecuente.
- Es fundamental el estudio de IFD basado en la detección de intensos depósitos de la fracción C3c, o de la fracción C3d, mediante técnicas de inmunohistoquímica (IHQ) Los depósitos de C3 pueden ser únicos o claramente predominantes (al menos dos órdenes de intensidad superior [escala de 0-3+]) sobre otros inmunorreactantes incluidas Ig y otros factores del complemento (C4c y C1q)2.
- Se deben excluir depósitos en glomérulos esclerosados y en focos de esclerosis segmentaria y necrosis fibrinoide, que pueden captar Ig y complemento de forma inespecífica.
- Descartar depósitos enmascarados con la utilización de IFD en parafina con proteasa (principalmente en pacientes >40 años).
- Descartar activación de otras vías del complemento (clásica y de las lectinas) mediante la tinción de IHQ para C4d.
- La localización de los depósitos en la ME es importante para distinguir la GNC3 y la EDD.